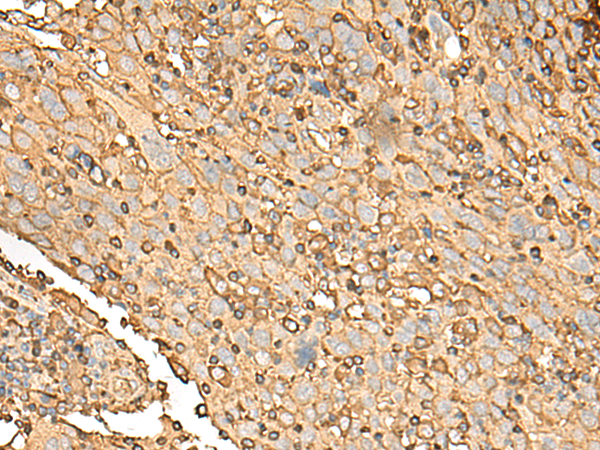

-
分类: 科研抗体货号: P09835别名: G1P2; IP17; UCRP; IFI15; IMD38; hUCRP应用: WB反应种属: Human
-
分类: 科研抗体货号: P09817别名: MST074; MSTP074应用: IHC反应种属: Human, Mouse
-
分类: 科研抗体货号: P09822别名: L28应用: IHC反应种属: Human, Mouse, Rat
-
分类: 科研抗体货号: P09833别名: C14orf159应用: WB,IHC反应种属: Human
-
分类: 科研抗体货号: P09815别名: SH3BGR; HEL-S-115应用: IHC反应种属: Human, Mouse
-
分类: 科研抗体货号: P09821别名: PDRG; C20orf126应用: IHC反应种属: Human, Mouse, Rat
-
分类: 科研抗体货号: P09832别名: L23A; MDA20应用: WB,IHC反应种属: Human, Mouse, Rat
-
分类: 科研抗体货号: P09814别名: TC1; TC-1; C8orf4应用: IHC反应种属: Human, Mouse
-
分类: 科研抗体货号: P09850别名:应用: IHC反应种属: Human
-
分类: 科研抗体货号: P09830别名: UBC2; HHR6A; MRXSN; RAD6A; MRXS30应用: IHC反应种属: Human, Mouse

鄂公网安备42018502007531号
鄂公网安备42018502007531号

